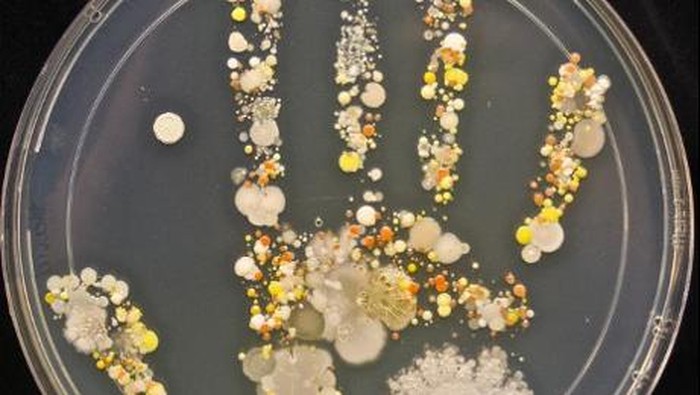

Jakarta -
Tak sekadar membuat kuku menjadi rusak dan tampak sangat pendek, hobi gigit-gigit kuku juga memberikan dampak lain bagi kesehatan.
Bukan hanya dilakukan saat stres, tak sedikit orang yang menjadikan gigit-gigit kuku sebagai kebiasaan harian. Hati-hati, efeknya tak cuma pada kuku tapi juga bagian tubuh lainnya seperti gigi.
Seperti dirangkum detikHealth dari Men's Health, berikut 5 efek buruk dari kebiasaan menggigiti kuku terhadap kesehatan:
ADVERTISEMENT
SCROLL TO CONTINUE WITH CONTENT
Baca juga: 5 Trik Cegah Mulut dari 'Bau Naga' di Pagi Hari
1. Infeksi
 Foto: Thinkstock
Foto: Thinkstock
|
Jika Anda menggigiti kuku terlalu dalam, maka bagian kulit halus di bawah kuku bisa menjadi terluka dan bahkan sampai berdarah. Kondisi ini tentu membuat bakteri atau patogen di dalam mulut serta lingkungan luar mudah masuk, yang berakibat pada infeksi.
2. Peradangan
 Foto: thinkstock
Foto: thinkstock
|
Komposisi kimia pada air liur mampu memecah lemak dan molekul makanan lainnya. Nah, kondisi ini disampaikan oleh pakar kesehatan kulit dari George Washington University, Adam Friedman, MD, dapat merusak kulit ujung jari Anda jika Anda terus-menerus menggigiti kuku.
"Untuk alasan yang sama, menjilati bibir Anda juga bisa membuatnya menjadi pecah-pecah. Ini adalah efek dari paparan air liur," tutur Friedman.
3. Memicu penyakit
 Foto: twitter
Foto: twitter
|
Kuku dan tangan dipenuhi oleh berbagai jenis bakteri dan kuman, maka dari itu menggigiti kuku dan memasukkan jari ke dalam mulut tentu dapat membuat bakteri tersebut berpindah tempat.
Paparan kuman ini dapat memicu berbagai jenis penyakit, mulai dari pilek, sampai nyeri di perut. Maka dari itu, hindari sebisa mungkin kebiasaan menggigiti kuku atau memasukkan jari ke dalam mulut ya.
4. 'Herpes jari tangan'
 Foto: ilustrasi/thinkstock
Foto: ilustrasi/thinkstock
|
Nama resminya adalah herpetic whitlow atau abses herpetik. Disebut dengan sebutan herpes karena kondisinya mirip seperti herpes pada umumnya, yakni berupa pembengkakan dan kemerahan di jari tangan, serta seringkali dibarengi dengan rasa nyeri.
Jika Anda memiliki infeksi herpes oral, maka menggigiti kuku dapat membuat jari Anda ikut terinfeksi oleh virus herpes tersebut. Gejala awalnya bisa berupa demam, rasa nyeri di ujung jari, serta muncul pembengkakan yang biasanya berisi cairan nanah atau darah.
5. Kerusakan gigi
 Foto: Thinkstock
Foto: Thinkstock
|
Tak cuma kerusakan pada kuku, kebiasaan gigit-gigit kuku juga turut memengaruhi kesehatan gigi Anda. Dalam jangka panjang, menggigiti kuku dapat membuat gigi rapuh, terkikis, dan bahkan memicu penyakit gusi.
Jika Anda menggigiti kuku terlalu dalam, maka bagian kulit halus di bawah kuku bisa menjadi terluka dan bahkan sampai berdarah. Kondisi ini tentu membuat bakteri atau patogen di dalam mulut serta lingkungan luar mudah masuk, yang berakibat pada infeksi.
Komposisi kimia pada air liur mampu memecah lemak dan molekul makanan lainnya. Nah, kondisi ini disampaikan oleh pakar kesehatan kulit dari George Washington University, Adam Friedman, MD, dapat merusak kulit ujung jari Anda jika Anda terus-menerus menggigiti kuku.
"Untuk alasan yang sama, menjilati bibir Anda juga bisa membuatnya menjadi pecah-pecah. Ini adalah efek dari paparan air liur," tutur Friedman.
Kuku dan tangan dipenuhi oleh berbagai jenis bakteri dan kuman, maka dari itu menggigiti kuku dan memasukkan jari ke dalam mulut tentu dapat membuat bakteri tersebut berpindah tempat.
Paparan kuman ini dapat memicu berbagai jenis penyakit, mulai dari pilek, sampai nyeri di perut. Maka dari itu, hindari sebisa mungkin kebiasaan menggigiti kuku atau memasukkan jari ke dalam mulut ya.
Nama resminya adalah herpetic whitlow atau abses herpetik. Disebut dengan sebutan herpes karena kondisinya mirip seperti herpes pada umumnya, yakni berupa pembengkakan dan kemerahan di jari tangan, serta seringkali dibarengi dengan rasa nyeri.
Jika Anda memiliki infeksi herpes oral, maka menggigiti kuku dapat membuat jari Anda ikut terinfeksi oleh virus herpes tersebut. Gejala awalnya bisa berupa demam, rasa nyeri di ujung jari, serta muncul pembengkakan yang biasanya berisi cairan nanah atau darah.
Tak cuma kerusakan pada kuku, kebiasaan gigit-gigit kuku juga turut memengaruhi kesehatan gigi Anda. Dalam jangka panjang, menggigiti kuku dapat membuat gigi rapuh, terkikis, dan bahkan memicu penyakit gusi.